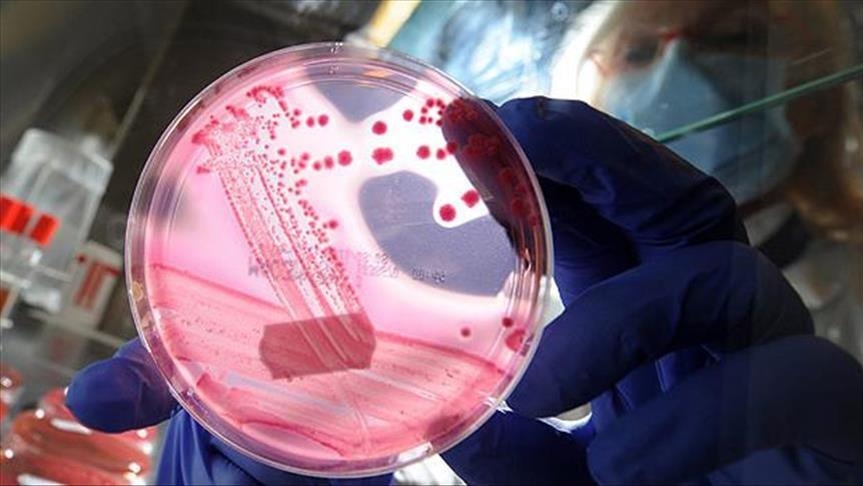
WHO: 'One in six deaths in 2015 from cancer globally'

WHO: 'One in six deaths in 2015 from cancer globally'
Some 8.8 million people died from cancer, representing one in six deaths globally in 2015, the World Health Organization said Friday, Anadolu Agency reports.
"One problem is that many cancer cases are diagnosed too late. Even in countries with optimal health systems and services, many cancer cases are diagnosed at an advanced stage, when they are harder to treat successfully," the WHO said in a report launched ahead of World Cancer Day on February 4.
"Diagnosing cancer in late stages, and the inability to provide treatment, condemns many people to unnecessary suffering and early death,” said Etienne Krug, Director of WHO’s Department for the Management of Noncommunicable Diseases, Disability, Violence and Injury Prevention.
By taking the steps to implement WHO’s new guidance, millions of people could be saved, Krug said in a press conference in Geneva.
"More than 14 million people develop cancer every year, and this figure is projected to rise to over 21 million by 2030," WHO said.
According to WHO statistics, the number of people who died from cancer increased by 27.5 percent comparing the year of 2000 with 2015. Nearly 7 million people died from cancer globally in 2000 while 8.8 million people died from cancer in 2015.
News.Az



























